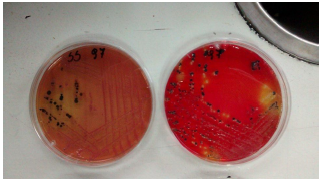

INTRODUCCIÓN
Las ETA causadas por Salmonella spp. son de notificación obligatoria en Argentina (Art. 2, Ley 15.465) y en muchos Estados Miembros de la OMS, pero entre ellas se incluye únicamente la Fiebre Tifoidea y Paratifoidea, cuyos agentes etiológicos son S. Typhi y S. Paratyphi, respectivamente. Por esta razón no se conocen cifras reales sobre el impacto de esta enfermedad en Argentina de casos de Salmonelosis no-tíficas. En Argentina, los datos disponibles de casos clínicos positivos a Salmonella spp. en humanos son aquellos publicados en los Boletines Epidemiológicos del Ministerio de Salud de la Nación, por el SINAVE (Sistema Nacional de Vigilancia Epidemiológica). Al considerar los escasos datos disponibles es evidente que S. Enteritidis es la más frecuentemente aislada de humanos y alimentos de consumo humano y animal (Caffer, Terragno, & Binsztein, 2008).
Salmonella spp. está presente en cerdos siendo una importante fuente de infección para humanos. Puede provocar enfermedad subclínica, diarrea leve, hasta una severa enfermedad sistémica. En el sistema de producción porcina las infecciones en cerdos están principalmente asociadas con los serovares S. Choleraesuis y S. Typhimurium (Mejía Silva, i Castillo, de Antonio, & María, 2005). La expresión de los genes de virulencia se inicia cuando Salmonella spp. entra en contacto con el medio ambiente hostil que representa el tracto gastrointestinal del huésped, donde encuentra una gran variedad de condiciones como la osmolaridad, la tensión de oxígeno y el pH. Estas actúan como señales para que inicie la transcripción de genes que codifican factores de virulencia, los cuales favorecen la interacción con la célula blanco durante la patogénesis (Hueck, 1998). La principal vía de transmisión de Salmonella spp. en los cerdos es la ruta fecal-oral. Tras su entrada por vía oral, es capaz de colonizar el tracto gastrointestinal y aparecer en heces lo que facilita la contaminación del ambiente y la transmisión entre animales. Los cerdos son reservorios de Salmonella spp. y existe un aumento de estos patógenos con el manipuleo de las canales en salas de desposte, ya que se considera que el medio ambiente del criadero y las instalaciones en las distintas etapas podrían ser hábitat de Salmonella spp. (Colello Rocio, 2016).
Actualmente hay 2.463 serotipos (serovares) de Salmonella (Rattanatabtimtong, 2007). Las fórmulas antigénicas de los serotipos de Salmonella son definidas y mantenidas por la OMS y el Centro Colaborador para Referencia e Investigación de Salmonella spp. en el Instituto Pasteur, París, Francia (colaborador de la OMS Centro).
Nuevos serotipos se enumeran en las actualizaciones anuales del esquema de Kauffmann-White.
Técnicas de detección de Salmonella spp.
La determinación de Salmonella spp. puede realizarse mediante diferentes métodos. Sin embargo, según la mayor parte de los estudios realizados, el cultivo micro-biológico y las pruebas bioquímicas son los procedimientos más comúnmente utilizados para el aislamiento de la bacteria a partir de tejidos y materia fecal. El método ideal debe tener una alta sensibilidad y especificidad, y ser al mismo tiempo simple, rápido y económico. Ningún método cumple con todos los criterios y es óptimo para todas las condiciones.
Es aconsejable apoyarse en los nuevos métodos de diagnóstico que están innovando para el aislamiento de Salmonella mediante el uso de pruebas moleculares como Reacción en Cadena de la Polimerasa (PCR) capaz de detectar un pequeño número de bacterias (102 a 104 UFC/ml) (Ward, Alinovi, Couetil, & Wu, 2005).
En la lucha contra las enfermedades infecciosas, la microbiología clínica necesita optimizar sus diagnósticos a nivel de especificidad, sensibilidad y rapidez. Entre las alternativas propuestas a estos retos, se estudiaron técnicas basadas en los principios de la Biología Molecular acortando los tiempos de entrega de los resultados. La PCR ha sido la principal herramienta diagnóstica. Los inicios de la PCR se remontan a 1971, cuando se describió por vez primera un método que usaba enzimas para replicar una secuencia pequeña de ADN in vitro. Sin embargo, este ensayo no recibió mucha atención y la autoría de la PCR fue atribuida 12 años después a Kary Mullis perteneciente a la Cetus Corporation, California S.A. La PCR representa una valiosa alternativa para el estudio de los genes a nivel mundial, en Salmonella spp. puede utilizarse para amplificar el gen invA, factor de virulencia ligado a la invasión (Luigi, Rojas, & Valbuena, 201 5). Los factores de virulencia son estructuras o metabolitos que producen daño o alteraciones metabólicas en la célula del hospedador. Algunas estructuras superficiales que podemos mencionar serian LPS, sistemas de secreción, fimbrias, entre otras. Estos factores se encuentran codificados en genes, localizados en el cromosoma o en plásmidos. Estos genes pueden estar en: islas de patogenicidad, genes aislados y plásmidos de virulencia. Las islas de patogenicidad de Salmonella spp. (IPS) se definen como largas agrupaciones de genes dentro del cromosoma bacteriano, que codifican para determinantes responsables de establecer las interacciones específicas con el hospedador y que son necesarias para la expresión de virulencia bacteriana en un modelo animal. Salmonella spp. tiene dos sistemas de secreción tipo III, codificados por dos islas de patogenicidad distintas IPS-1 e IPS-2. Los sistemas de secreción tipo III, son un grupo de estructuras especializadas de algunos géneros de bacterias Gram negativas, cuya finalidad es introducir proteínas efectoras al cito-sol de células eucariotas con el fin de desequilibrar su función (Hueck, 1998). El gen invA codifica un factor de virulencia relacionado con el proceso de invasión al epitelio intestinal durante el proceso de infección. Es común en todas las variedades invasoras, esto significa que se puede asociar con posibles cuadros virulentos (Zhang et al., 2002) (Malorny, Hoorfar, Bunge, & Helmuth, 2003).
Otro método de diagnóstico utilizado, que permite obtener resultados rápidos de detección de Salmonella spp. es la técnica inmunocromatográfica. Se trata de una prueba cualitativa en la que la muestra reacciona con los conjugados coloreados (anticuerpos anti-Salmonella). Este complejo avanza por capilaridad a través de la membrana del test y en caso de ser positiva, se observa como una línea de color rojo en la zona de resultado de la membrana.
El objetivo de este estudio fue utilizar diferentes métodos moleculares, fenotípicos e inmunocromatográficos para la detección de Salmonella spp. en canales porcinas.
MATERIALES Y MÉTODOS
Se realizaron esponjados de 60 canales porcinas, que posteriormente fueron cultivados en agua de peptona. Se conservó 1 ml de cada cultivo con glicerol a -70°C para futuros estudios.
Se realizó PCR para el gen invA de cada muestra directamente del cultivo de zona confluente. Simultáneamente las muestras se procesaron para detección de Salmonella spp. por los métodos microbiológicos convencionales y a partir de colonias aisladas se realizaron pruebas bioquímicas y PCR para detección del gen invA.
Aislamiento e identificación de Salmonella spp.
El aislamiento de Salmonella spp. se realizó según Normas ISO 6579:2002 con algunas modificaciones. Brevemente, se extrajo una alícuota de cada muestra criopreservada y se cultivó en 3 ml de caldo Luria Bertani (LB) durante 24 h a 37°C. Se inoculó 1 ml del caldo LB en 9 ml de caldo Rappaport y se incubó a 42°C durante 24 h. Se sembró una alícuota del caldo Rappaport con ansa en anillo sobre la superficie del medio hasta agotar por estría en placas de agar Salmonella-Shigella (S-S) (Britania) y agar Xilosa-Lisina-Tergitol 4 (XLT4) (Merck) incubándose por 37 °C durante 24h.
Se seleccionaron colonias típicas de Salmonella spp. y se cultivaron para ser confirmadas mediante pruebas bioquímicas y PCR.
Pruebas bioquímicas. Se realizaron pruebas bioquímicas convencionales para detección de Salmonella spp.: agar hierro tres azúcares (TSI) (Britania), agar lisina hierro (LIA) (Britania), urea (Britania), Fenilalanina-Desaminasa (FAD) (Britania), Orto-nitrofenilgalactopiranosido (O.N.P.G.).
Amplificación por PCR. Las colonias presuntivas a Salmonella obtenidas por los métodos fenotípicos convencionales se colocaron en 500 |j[ de agua bidestilada, llevándose a ebullición durante 10 min para liberación de ADN y posterior detección del gen invA por PCR.
Las cepas se conservaron a -70°C para sus futuras caracterizaciones.
Para la detección del gen se utilizó como control positivo la cepa Salmonella Dublín (invA+) proveniente del laboratorio de Microbiología Clínica y Experimental de la Facultad de Ciencias Veterinarias de la UNCPBA.
Condiciones del ensayo. El cóctel de reacción de PCR se realizó en una solución de KCl 50 mM, Tris-HCl 10 mM pH 9, Tritón X-100 al 0,1%, MgCb 2 mM, 0,01% de gelatina, 0,2 mM de cada dNTP, 1 |M de cada primer, 1U de Taq DNA polimerasa (Highway®) y 5 µl de ADN.
Las condiciones de termociclado empleadas en la detección del gen invA fueron las siguientes:
Temperatura y tiempo inicial: 94°C 10min.
94°C 1 min
ciclos 2 a 30 60°C 1 min
72°C 2 min
Temperatura y tiempo final: 72°C 10 min.
La secuencia de primers empleados, tamaño de los productos amplificados y referencia bibliográfica se detallan en la tabla 1.
La reacción de PCR se efectuó en un termociclador programable: T-17 Ivema. Los productos de la reacción se analizaron por electroforesis en un gel de agarosa al 2% en presencia de bromuro de etidio. El tamaño de las bandas se determinó comparando los productos amplificados con el marcador de tamaño molecular DNA Ladder 100 bp (Promega®), que consta de 11 fragmentos con tamaños de 100 a 1500 pb, de los cuales la banda de 500 pb contiene el triple de concentración molar que el resto y sirve como un visible indicador de referencia.
Inmunocromatografía. Las muestras que dieron resultados positivos para PCR, ya sea directo de zona confluente o a partir de colonias individuales, independientemente del resultado que se haya observado en las pruebas bioquímicas fueron sometidas a un test de inmunocromatografía (RapidCheck® SELECT).
RESULTADOS
De 60 muestras, una resultó positiva a invA por PCR directo de zona confluente. Sin embargo, cuando se analizaron por PCR colonias compatibles con la morfología de Salmonella luego de sembrar las muestras en medios selectivos, se obtuvieron 6 aislamientos positivos al gen invA (10%).
De las 60 muestras, por pruebas bioquímicas se identificaron 5 aislamientos que fueron confirmadas como Salmonella spp., mientras que 2 aislamientos fueron clasificadas como sospechosas de S. Arizonae y S. Diarizonae ya que el O.N.P.G no dio resultado característico para Salmonella spp.
Se realizó Inmunocrmatografía a las 7 muestras positivas por PCR y pruebas bioquímicas, y únicamente 3 manifestaron bandas de color en la prueba de cromatografía.
A continuación en la tabla 2 se detallan los resultados obtenidos por pruebas bioquímicas.
DISCUSIÓN
Diversos estudios han demostrado la prevalencia y se-roprevalencia de Salmonella spp. en granjas porcinas, así como los factores de riesgo asociados a la presencia de la bacteria y la prevalencia en canales en las plantas de sacrificio y en expendios de carne porcina (Colello Rocio, 2016) (Gonzales-Barron, Redmond, & Butler, 2012) (Methner, Rammler, Fehlhaber, & Rósler, 2011). Estos estudios se centraron en la utilización de pruebas bioquímicas de identificación. Al momento de elegir la metodología, se evalúa una serie de aspectos como la inversión inicial, el costo operacional y la urgencia en la obtención de resultados, entre otros.
Los criterios para la identificación bioquímica de Salmonella spp. están ampliamente descriptos y la detección de Salmonella spp. por cultivo convencional es considerada el método de referencia, sin embargo, esta técnica presenta como desventaja el tiempo requerido para la obtención de un resultado (Chacón, Barrantes, García, & Achí, 2010). Estas pruebas dependen de la expresión fenotípica de las características analizadas y pueden estar afectadas por variaciones en los medios de cultivo y en las condiciones de incubación. Como alternativa se están utilizando cada vez más los métodos moleculares; que permiten un diagnóstico más rápido y simple de realizar (Caffer et al., 2008), siendo la detección de positivos mayor por PCR que por pruebas bioquímicas (tabla 3). Por ejemplo, en las muestras 13 y 27, las pruebas bioquímicas dieron resultados dudosos para Salmonella spp., siendo confirmada como tal al obtener un resultado positivo para el gen InvA por PCR con primers específicos para Salmonella spp. La utilización de los discos O.N.P.G no presenta excepciones a la hora de mencionar ciertas limitaciones. Por un lado, se recomienda realizar en paralelo un control positivo y un control negativo; y por otro es necesario trabajar con un inóculo denso del microorganismo para incrementar la velocidad de la reacción.
Tabla 3 Comparación de pruebas bioquímicas, PCR e inmunocromatografía

*: Sospechosa de cepas S. Arizonae y S. Diarizonae
La amplificación del gen ; InvA, uno de los genes descriptos en todas las cepas de Salmonella spp. se basa en la utilización de un par de primers que amplifican un segmento específico de Salmonella spp, como ya ha sido mencionado en estudios similares (Malorny et al., 2003) (Chacón et al., 2010) (Espinal Marin, Prieto Suárez, Otero Jiménez, & Máttar Velilla, 2006). De esta manera se obtienen resultados certeros que permitirían confirmar aquellos considerados dudosos mediante pruebas bioquímicas.
Se ha descrito que la utilización de métodos rápidos por inmunocromatografía puede dar resultados negativos falsos (tabla 3). Se deben tener en cuenta ciertos factores intrínsecos dependientes de la matriz alimentaria que podrían llevar a resultados erróneos. Por lo tanto la selección de un método rápido de detección de Salmonella spp. debe hacerse luego de determinar el grado de riesgo que se desea correr (Killner, 2008).
La confirmación de colonias presuntivas (10%) de Salmonella spp. en 60 muestras demuestra la importancia de incorporar técnicas de diagnóstico que requieran menor tiempo a las que se establecen en las Normas, tales como ISO 6579:2002, ya que el tiempo de detección por métodos moleculares fue menor y notablemente menos laborioso con respecto al tiempo requerido para la realización de pruebas bioquímicas.
Económicamente el costo operativo para la realización de la técnica por PCR fue mayor, teniendo en cuenta en primer lugar el costo inicial del equipamiento técnico que se requiere y sumando luego los reactivos utilizados durante la ejecución del ensayo. Sin embargo, el tiempo empleado para hacer la prueba y el tiempo que demora el resultado es menor que para los métodos microbiológicos tradicionales.
CONCLUSIÓN
La utilización de diferentes métodos para la identificación de Salmonella spp. presenta variabilidad en tiempo, recursos y, en algunos casos, en los resultados obtenidos por cada uno. Las pruebas bioquímicas implican mayor tiempo de obtención de resultados y gran cantidad de material y medios de cultivo. La inmunocromatografía requiere una concentración mayor de Salmonella spp. para obtener resultados fiables. Por lo tanto, resulta necesario incorporar técnicas de diagnóstico que requieran menor tiempo a las que se establecen en las Normas ISO 6579:2002, como los métodos moleculares, para obtener un diagnóstico de contaminación con rapidez y confiabilidad. La detección rápida ante la sospecha de Salmonella spp. es el aspecto central para disminuir la potencial contaminación y evitar que por medio de los alimentos u otras vías llegue a la población y cause enfermedad.